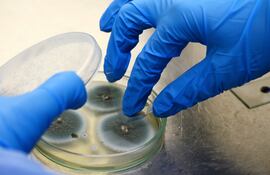
Hongo aspergillus flavus en el laboratorio, imagen ilustrativa.

6 de febrero de 2026

La australiana Erin Patterson, de 50 años, fue hallada culpable este lunes por un jurado de tres delitos de asesinato y uno de tentativa, tras servir lomos Wellington con hongos tóxicos a cuatro familiares, en un mortal banquete en su casa al sureste de Melbourne en julio de 2023.
Un hongo letal vinculado a muertes en tumbas antiguas podría salvar vidas: científicos transformaron moléculas del Aspergillus flavus, conocido por dañar cultivos y liberar toxinas mortales, en un prometedor compuesto anticancerígeno.

BRUSELAS. Las setas se imponen como superalimento sostenible: necesitan poca agua, casi no generan huella de carbono y están cargadas de nutrientes. Pero el verdadero héroe es el micelio, una red subterránea clave para capturar CO₂ y sostener la salud del planeta.

BANGKOK. El único superviviente de una cena con hongos tóxicos en Australia, Ian Wilkinson, dijo este martes durante el juicio que la acusada de envenenar a tres personas con la comida, Erin Patterson, negó la ayuda que sus comensales le ofrecieron en la cocina.